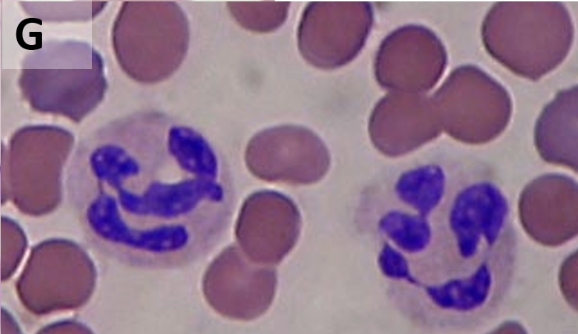
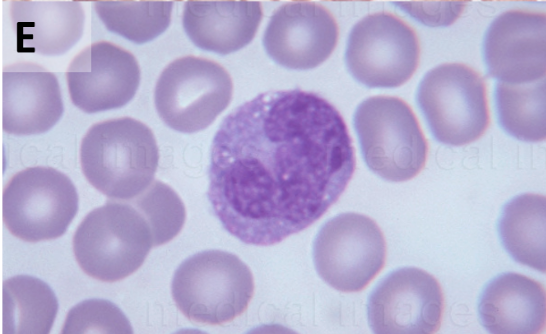
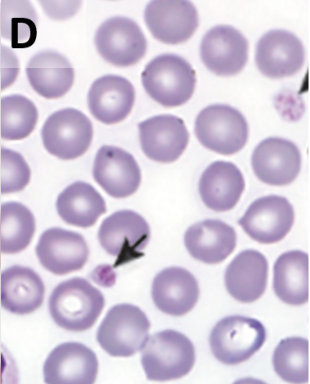
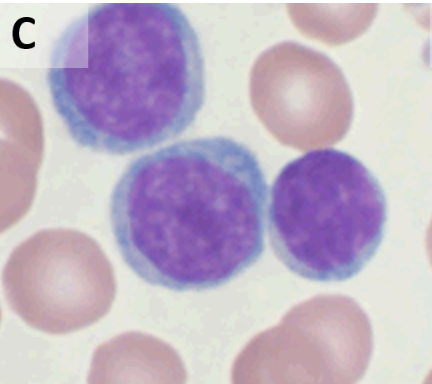
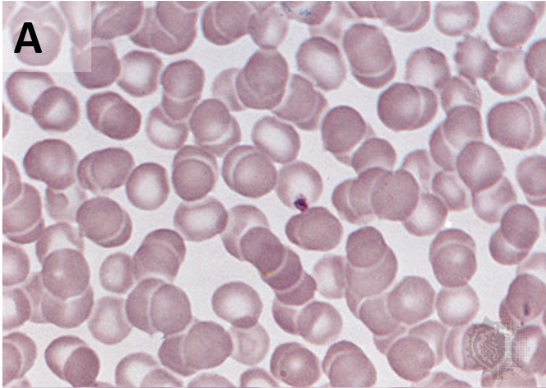
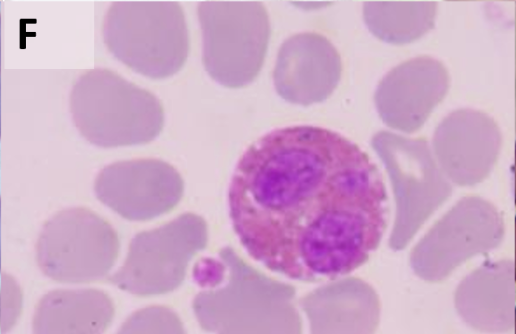
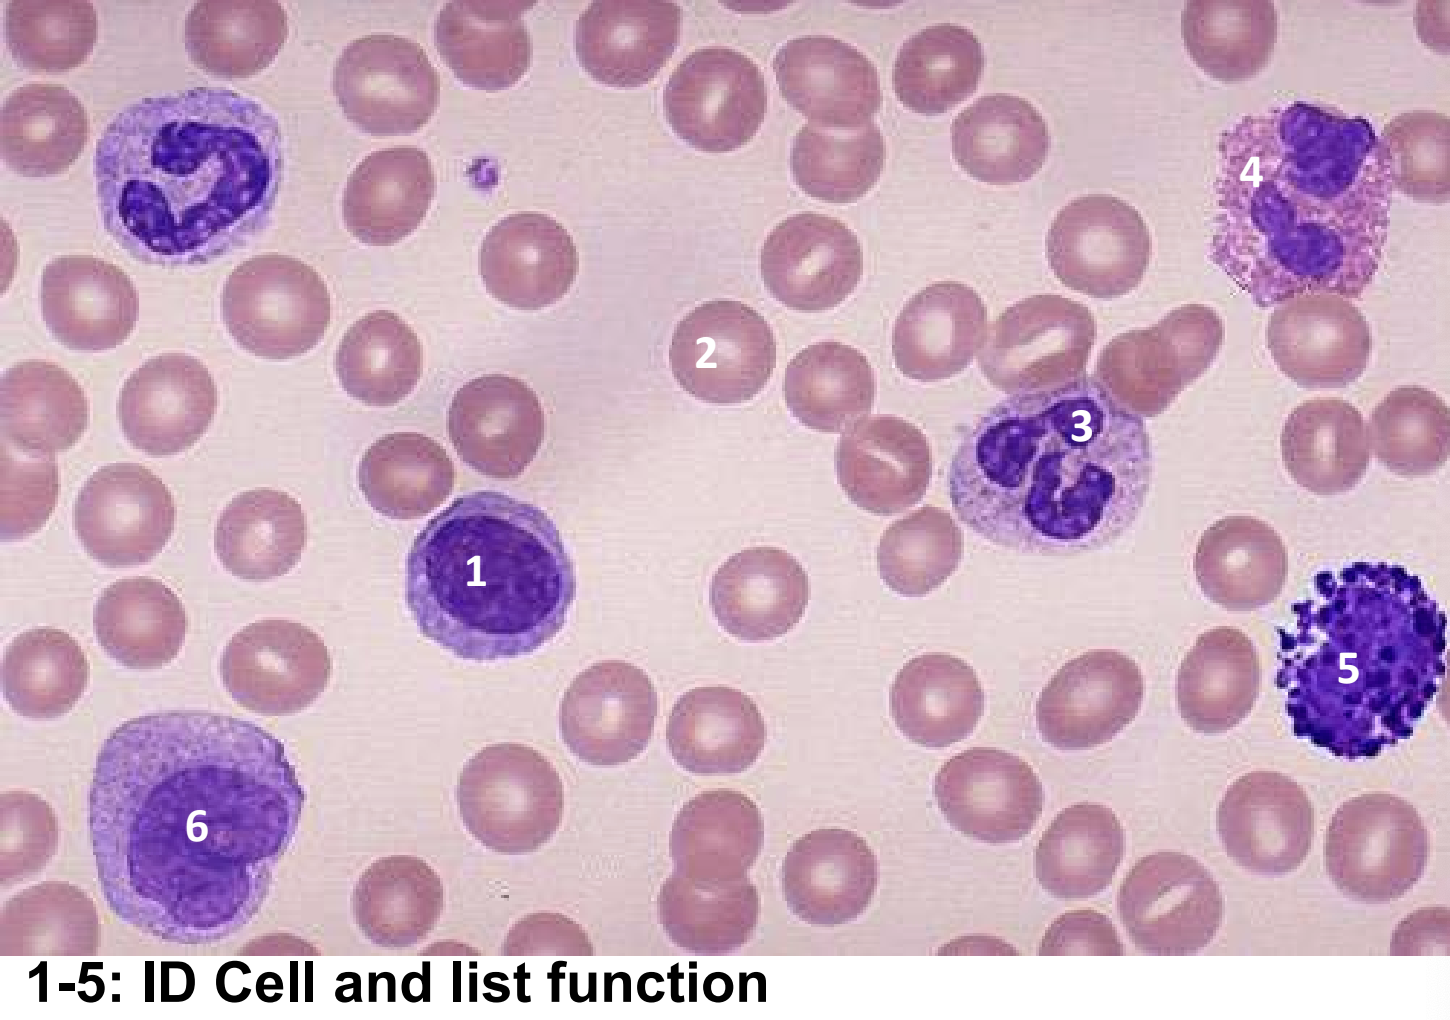

Blood Lab Quiz
1/44
There's no tags or description
Looks like no tags are added yet.
Name | Mastery | Learn | Test | Matching | Spaced | Call with Kai |
|---|
No analytics yet
Send a link to your students to track their progress
45 Terms
Identify the blood cell
Neutrophil
Identify the blood cell
Monocytes

Identify the blood cell
Basophils
Identify the blood cell
Platelets
Identify the blood cells
Lymphocytes
Identify the blood cell
Red Blood Cells
Identify the blood cell
Eosinophils
What is the order of WBCs from greatest to least?
Neutrophils, Lymphocytes, Monocytes, Eosinophils, Basophils
Never Let Monkeys Eat Banana
What is the Normal Packed Cell Volume (PCV) or hematocrit range for females? What is the average %?
normal range: 38% - 46%
average: 42%
What is the Normal Packed Cell Volume (PCV) or hematocrit range for males?
normal range: 40% - 54%
average: 46%
Micro Hematocrit or PCV
determines what proportion of whole blood is composed of cells and what proportion is composed of plasma
PCV
Packed Cell Volume
Why do males have higher hematocrit?
testosterone; stimulates the bone marrow to produce more red blood cells
What is the percentage of Neutrophils?
60%
What is the percentage of Lymphocytes?
30%
What is the percentage of Monocytes?
5%
What is the percentage Eosinophils?
2%
What is the percentage Basophils?
>0.5%
1-5: Identify cells and list functions
Lymphocytes: T, B, NK Cells; cancer cells
RBC: oxygen transport, CO2 removal
Neutrophils; phagocytes that kills and ingest bacteria and fungi
Eosionophils; targets parasitic bacteria
Basophils; releases histamine to trigger inflammation during allergic reaction or fever
Monocytes; MACROphages that engulf bacteria, viruses, and dead cells

Identify blood type?
From which donors could this person receive blood?
AB-
donors with AB-, A-, B-, or O- blood types

How to calculate PCV using a ruler?
PCV of a male?
Divide the first line of where the blood stops by the second line of where the plasma stops
example:
2.7/5.5 = 49%
What does it mean when the blood sample clumps or agglutinate?
Indicates presence of the antigen of the blood
Ex: Anti A Serum clumps = Precense of A antigens
Ex: Anti A Serum does not clump = No A antigens
What does it mean if the Anti-D (Rh) serum clumps or agglutinate?
Clumping = Positive (+positive+); The red blood cells have the Rh protein.
No Clumping = Negative ( −negative−): The red blood cells lack the Rh protein.
What is the universal donor?
O negative
What is the universal recepient?
AB positive
What blood can AB+ receive?
ALL —— (A+, A-, B+, B-, O+, O-, AB+, AB-).
What blood can AB- receive?
AB-, A-, B-, O-
What blood can A+ receive?
A+, A-, O+, O-
What blood can A- receive?
A-, O-
What blood can B+ receive?
B+, B-, O+, O-
What blood can B- receive?
B-, O-
What blood can O+ receive?
O+, O-
What blood can O+ receive?
O+, O-
Neutrophils function
most abundant; 1st responder to bacterial infections; kill phagocytosis & respiratory burst
Lymphocytes functions
agranular; fighting infections, destroying cancer cells, and creating immunological memor
B Lymphocytes (B cells): Produce antibodies that neutralize pathogens like bacteria, viruses, and toxins.
T Lymphocytes (T cells): Destroy the body's own cells that have been infected by viruses or turned cancerous.
Natural Killer (NK) Cells: Act as rapid responders, identifying and killing abnormal or cancerous cells in the early stages
Monocytes functions
u shape nucleus; differentiate into MACROphages; big phagocytoic eating cells; destroy microbes and clean up dead tissue following an infection
Eosinophils Functions
orange/pink stain granuals; deal with large parasitic infections like worms; attack and destroy large infectious bodies; mediate severity of allergic reactions) reduce inflammation caused by basophils)
Basophils function
granular leuokcyte; dark purple; secrete histamine which causes inflammation associated with fever
Cause of low hematocrit
Anemia: low RBCs
Cause of high hematocrit
Polycythemia; high RBCs
Normal range percentage of Neutrophils
40%-60%
Normal range percentage of Lymphocytes
20%-40%
Normal range percentage of Monocytes
2%-8%
Normal range percentage of Eosinophils
1%-4%
Normal range percentage of Basophils
0.5% -1%